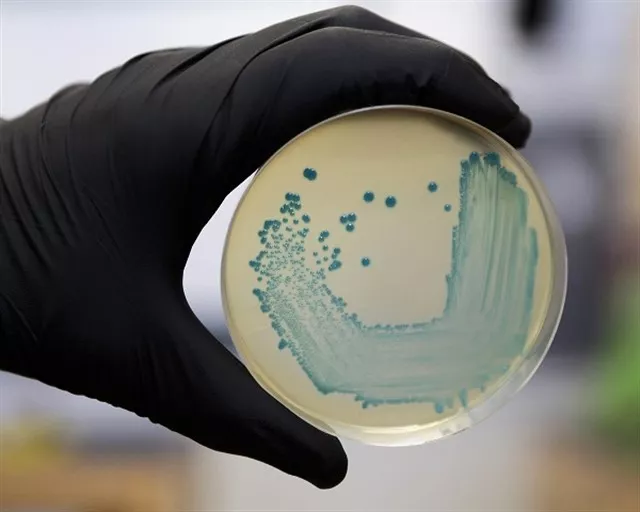

Un solo ingresado por listeriorisis en la provincia
En total hay 10 afectados en Cádiz sobre un total de 196 casos confirmados en Andalucía desde el inicio de la alerta
La Consejería de Salud y Familias ha informado de que este martes se han confirmado tres nuevos casos de infección por Listeria monocytogenes localizados en Sevilla, con lo que la cifra de afectados desde el inicio de la alerta es de 196, mientras que el número de pacientes ingresados en los hospitales públicos y privados con sospecha de infección o con infección confirmada se ha reducido un 20% en 24 horas. Así, el número de personas hospitalizadas este lunes por la noche era de 86 cuando el día anterior se elevaba a 108.
En concreto, según un comunicado del departamento que dirige Jesús Aguirre, este lunes se confirmaron tres nuevos casos de infección por Listeria monocytogenes localizados en Sevilla. En total, el número de personas con infección confirmada desde el inicio de la alerta, decretada el pasado 15 de agosto, es de 196 (el día anterior era de 193). La mayoría de estos casos se localizan en la provincia de Sevilla, 161 (82,1%), seguida de Huelva (17 casos), Cádiz (10), Málaga (4) y Granada (4). En las provincias de Almería, Córdoba y Jaén no hay casos confirmados.
Por su parte, los pacientes ingresados en los hospitales públicos este lunes eran 68 (frente a los 83 del día anterior). De ellos, 26 son mujeres embarazadas (28 el día anterior) que están en tratamiento antibiótico y tres pacientes permanecían ingresados en UCI (igual que el día anterior). En estas últimas 24 horas no se han producido muertes ni abortos ni infecciones en recién nacidos.
En cuanto a la distribución por provincias de estos pacientes ingresados en Sevilla son 46 (el día anterior 61), Huelva, 15 (14 en la jornada anterior); Cádiz, 1 (2 el día anterior); Málaga, 4 (3 el día anterior); Córdoba, 1 (2 el día anterior); y Granada, 1 (el mismo número que el día anterior). En Jaén y Almería no hay pacientes ingresados.
El número de pacientes hospitalizados en los hospitales privados con sospecha de infección por Listeria monocytogenes es de 18 (25 el día anterior). De ellos, 5 son mujeres embarazadas (6 el día anterior) y un ingreso en UCI. La distribución por provincias de estos pacientes es la siguiente: Sevilla, 15 (22 el día anterior) y Cádiz, 3 (igual que en el día anterior).
Asimismo, la frecuentación a los servicios de urgencias se ha mantenido este lunes en los valores normales para esta época del año.
El portavoz del gabinete técnico creado por la Consejería de Salud y Familias para el seguimiento del brote de listeriosis, José Miguel Cisneros, ha señalado que "los datos de los cuatro últimos días indican que se ha producido la inflexión del brote, aunque aún no se ha terminado". Cisneros ha incidido en que "lo esperable es que la reducción del número de casos se acentúe en los próximos días para entrar en una fase con casos poco frecuentes que puede durar hasta el mes de octubre incluido".
El consejero de Salud y Familias de la Junta de Andalucía, Jesús Aguirre, ha explicado la gestión del Gobierno andaluz en torno al brote de listeriosis en la reunión del Consejo Interterritorial del Sistema Nacional de Salud celebrada este lunes. Aguirre ha resaltado que esta actuación ha sido "totalmente transparente" e "impecable".
El consejero ha indicado que se ha retirado todo el producto afectado "en el menor tiempo posible".
En el encuentro, el consejero ha expuesto que las prioridades del Gobierno andaluz han sido determinar el origen de la listeria; retirar del mercado el alimento causante y evitar infecciones cruzadas; de forma muy especial, facilitar toda la información verificada y disponible a los ciudadanos de la forma más rápida posible y disponer de todos los medios necesarios para atender a las personas afectadas.
LA ALERTA SANITARIA
El día 15 de agosto, la Consejería de Salud y Familias, a través de la Dirección General de Salud Pública y Ordenación Farmacéutica, decretó la alerta sanitaria sobre el producto de carne mechada con el nombre comercial 'La Mechá', fabricado por la firma Magrudis, con domicilio en Sevilla capital, tras comprobar que este producto era el agente causante de los brotes de listeriosis registrados en las últimas semanas.
Desde ese momento, la Consejería ha informado a los ciudadanos de que dejen de consumir ese producto, sobre el que la Consejería procedió entonces a su inmovilización y retirada del mercado. La producción de la carne mechada de 'La Mechá' quedó paralizada el 14 de agosto.
El pasado viernes 23 de agosto, la Consejería de Salud y Familias amplió la alerta sanitaria a los productos distribuidos por la empresa Comercial Martínez León que comercializa la carne mechada fabricada por Magrudis, con una presunta infracción sobre el etiquetado y a la información sobre el origen de la carne. Al tiempo, la Consejería ha procedido a la inmovilización del producto en las instalaciones de esta distribuidora y a la retirada del mismo.
Salud y Familias ha remitido una denuncia a la Fiscalía por este reenvasado de los productos de Magrudis. Asimismo, la Consejería ha ampliado la alerta a todos los productos de la empresa Magrudis.
CONSEJOS A LA POBLACIÓN
La Consejería de Salud y Familias recuerda a los ciudadanos y sobre todo a las personas de riesgo que han comido o sospechan que pueden haber consumido el alimento contaminado que consulten sin demora si presentan síntomas de infección.
Además, se recuerda la necesidad de seguir unas medidas higiénicas básicas y especialmente las relacionadas con los alimentos. Igualmente, la Consejería agradece la contribución de la población por el uso responsable de los servicios sanitarios y resalta la excelente labor que están realizando los profesionales del sistema sanitario.